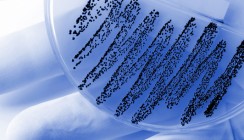

Branchenmeldungen 09.09.2013
Wechsel an der Spitze: IADR mit neuem Präsidenten
Sprachrohr der zahnmedizinischen Forschung
Professor Dr. Gottfried Schmalz vom Universitätsklinikum Regensburg (UKR) wurde zum Präsidenten der Paneuropäischen Region der International Association for Dental Research (IADR) gewählt und unterstützt in dieser Funktion die zahnmedizinische Forschung in Europa und Israel.
Die International Association for Dental Research
ist ein Verbund von Wissenschaftlern der Zahnmedizin, der 1920
gegründet wurde und mit mehr als 12.000 Mitgliedern weltweit die
zahnmedizinische Forschung unterstützt. Professor Dr. Gottfried Schmalz,
Direktor der Poliklinik für Zahnerhaltung und Parodontologie des
Universitätsklinikums Regensburg, wurde nun zum President-elect der
Paneuropäischen Region (Europa und Israel) gewählt.
„Damit erwartet mich eine spannende Aufgabe und große Herausforderung,
denn die zahnmedizinische Forschung ist innerhalb Europas und in Israel
in unterschiedlichen Entwicklungsstadien. Hier mehr Fortschritt für die
Zahngesundheit zu erreichen, ist mein Ziel“, erläutert Professor
Schmalz. Als President-elect und ab September 2014 als Präsident der
Paneuropäischen Region vertritt er diese im Weltverband IADR. Ein
weiteres Ziel seiner Arbeit wird es sein, bei der Europäischen Union in
Brüssel das Thema Mundgesundheit vermehrt in das Bewusstsein zu rücken.
„Trotz nachweisbarer Erfolge in der Karies-Prophylaxe gehören Karies und
Zahnfleischerkrankungen noch immer zu den häufigsten chronischen
Erkrankungen. Auch Tumoren der Mundhöhle stellen uns vor große
Herausforderungen. Zum Thema Mundgesundheit gibt es noch sehr viel
Forschungsbedarf“, erläutert Professor Schmalz. Vor allem gemeinsame
Anstrengungen über Ländergrenzen hinweg seien wichtig, um die
verschiedenen Kompetenzen zu bündeln und auch die nötigen finanziellen
Mittel zu erhalten.
Professor Schmalz ist seit
Gründung der Fakultät für Medizin der Universität Regensburg im Jahr
1983 Inhaber des Lehrstuhls für Zahnerhaltung und Parodontologie. In den
30 Jahren seiner Tätigkeit wurden am UKR mehr als 1.500 Zahnmediziner
ausgebildet. Aufgrund seines wissenschaftlichen Engagements kann
Professor Schmalz nun seine langjährigen Erfahrungen auf internationaler
Ebene weiter einbringen.
Quelle: Universitätsklinikum Regensburg (UKR)